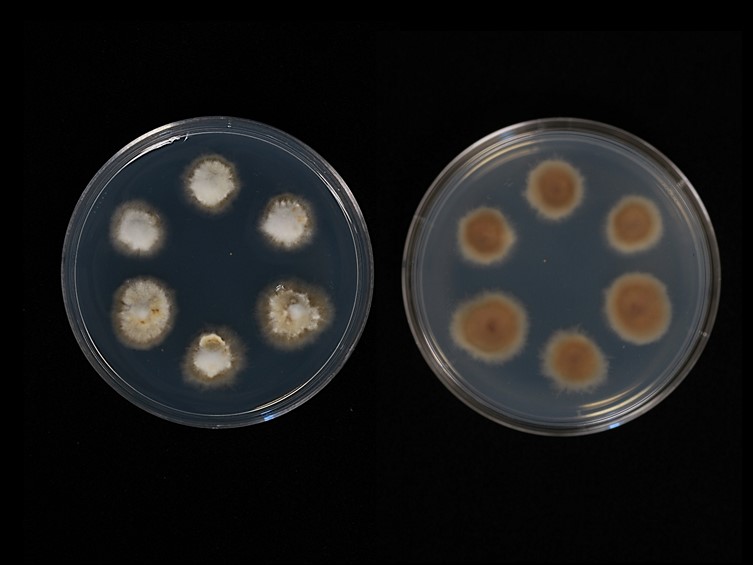

Habitat:
Leaf litter.
Host:
On Hymenoptera (wasp).
Description:

Stroma arising from any point on the insect but usually from between the head and thorax, up to 45 mm long including the head. 
Fertile heads terminal, citriform to cylindric, chraceous to cream yellow. 
Perithecia oblique to the walls of the fertile head but with a distinctive curve on the neck ending almost at right-angles to the outer wall of the head, 880–1000 × 200–260 μm with no evidence of a hamathecium. 
Asci hyaline, filiform, at least 700 μm long and up to 7 μm wide with a prominent apical cap. 
Ascospores broke readily into hyaline, fusoid part-spores, 10–14 × 1.5–2.5 μm. Asexual morph: Hymenostilbe on the terminal part of the stroma. Conidiogenous cells cylindrical, 10–20 × 3–6 μm with one to three stout denticles. Conidia broadly clavate, strongly apiculate, 3–10 × 3–4.5 μm.
Culture characteristics:
Colonies on PDA attaining a diam of 10 mm in 14 d, hyaline to pale grey brown with only sparse aerial mycelium, reverse grey-white to pale grey brown. Several stout synnemata developed after 20 d, similar to the stromata on the hosts.
Species |
Strain |
Compound |
Pubchem CID |
Biological activity |
Reference |
|---|
|
Strain |
- |
|---|---|
| NBRC 101752 | JN941445 |
| NBRC 101753 | JN941446 |
| OSC 110998 | DQ518765 |